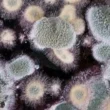

مقدمة في شهر رمضان
شهر رمضان هو شهر الرحمة والمغفرة، وهو موسم لتلاوة القرآن الكريم وتدبر معانيه، وشهر الجود والكرم والعطاء، وشهر الصبر والجلد، وشهر الطاعات والأعمال الصالحة التي تقربنا إلى الله، وشهر البركات والخيرات الوفيرة. إنه حقًا مدرسة تربوية فريدة تغرس في نفوسنا القيم النبيلة والأخلاق الحميدة. في هذا الشهر الفضيل، تتجلى العديد من الفضائل التربوية التي تؤثر بشكل إيجابي على سلوكنا وأخلاقنا، والتي سنتناول بعضًا منها في هذا المقال.
القيم التربوية لصيام شهر رمضان
الصيام في شهر رمضان يحمل في طياته العديد من الدروس والعبر التي تثري شخصية المسلم وتساهم في بنائه الروحي والأخلاقي. من أبرز هذه الفضائل:
- اكتساب فضيلة الصبر: الامتناع عن الطعام والشراب والملذات، والتحمل في وجه العطش والحرارة لمدة شهر كامل، يعزز قدرة الفرد على الصبر والتحمل. يصبح المسلم بعد رمضان أكثر قوة في مواجهة التحديات والصعاب، ويتعلم كيفية التحكم في نفسه وتأجيل رغباته.
- الاستجابة لأوامر الله وتجنب نواهيه: يلتزم المسلم خلال شهر رمضان بالصيام والقيام وقراءة القرآن، ويحرص على غض البصر وحفظ اللسان، مما يعزز لديه الالتزام بتعاليم الدين والابتعاد عن المحرمات.
- تنمية الجود والكرم: يشجع شهر رمضان على الإنفاق على الفقراء والمحتاجين، وتقديم المساعدة للآخرين، والمشاركة في الأعمال الخيرية، مما ينمي روح العطاء والكرم في المجتمع.
- إخلاص النية لله تعالى: يحرص المسلم في رمضان على أن تكون جميع أعماله خالصة لوجه الله تعالى، وأن يبتغي مرضاته في كل ما يفعل، مما يعزز لديه الإخلاص والصدق في النية.
- زرع روح التنافس في الطاعات: يشجع شهر رمضان على المسارعة إلى فعل الخيرات والأعمال الصالحة، والتنافس في الطاعات، مما يؤدي إلى زيادة الخير والبركة في المجتمع.
- تنمية الرحمة والتعاطف: يساعد الصيام على الشعور بمعاناة الفقراء والمحتاجين، مما يزيد من الرحمة والشفقة في القلوب، ويدفع إلى تقديم المساعدة والدعم لهم.
- تقبل التغيير والتكيف مع المستجدات: يعلمنا رمضان كيفية التكيف مع الظروف الجديدة، والتعامل مع التحديات، وعدم الجمود على الأساليب القديمة.
- المحافظة على أداء الفرائض: يحرص المسلم في رمضان على أداء جميع الفرائض في وقتها، وعدم التفريط فيها أو تأخيرها، مما يعزز لديه الالتزام بالدين.
- تعزيز الوحدة والتآلف: يجتمع المسلمون في رمضان على الصيام والإفطار وأداء الصلوات، مما يعزز الوحدة والتآلف بينهم، ويقوي الروابط الاجتماعية.
- التحكم في الانفعالات والغضب: يساعد الصيام على التحكم في الانفعالات والغضب، والتحلي بالهدوء والسكينة، مما يحسن العلاقات الاجتماعية.
- استغلال الوقت في النافع: يشجع شهر رمضان على استغلال الوقت في قراءة القرآن والذكر والدعاء، والابتعاد عن اللهو والعبث، مما يزيد من البركة في الوقت.
- التحلي بالأخلاق الحسنة: يعلمنا رمضان كيفية التحلي بالأخلاق الفاضلة، مثل الصدق والأمانة والتواضع، والابتعاد عن الأخلاق السيئة، مثل الكذب والغش والكبر.
- الالتجاء إلى الله تعالى: يشجع شهر رمضان على الدعاء والتضرع إلى الله تعالى، وطلب العون منه في كل الأمور، مما يعزز العلاقة بين العبد وربه.
- التواضع والابتعاد عن التكبر: يعلمنا رمضان كيفية التواضع والابتعاد عن التكبر والغرور، والتواضع للناس، مما يزيد من المحبة والتقدير في المجتمع.
- مراقبة النفس ومحاسبتها: يشجع شهر رمضان على مراقبة النفس ومحاسبتها على الأفعال والأقوال، والتوبة إلى الله تعالى من الذنوب والمعاصي.
- القناعة والرضا: يعلمنا رمضان كيفية القناعة بما رزقنا الله تعالى، والرضا بالقدر، وعدم الطمع في المزيد.
- بث روح التعاون: يشجع شهر رمضان على التعاون بين أفراد الأسرة والمجتمع في الأعمال الخيرية والإنسانية.
- مساعدة العاصين على التوبة: يشجع شهر رمضان على تقديم النصح والإرشاد للعاصين، ومساعدتهم على التوبة والرجوع إلى الله تعالى.
- شكر الله تعالى: يعلمنا رمضان كيفية شكر الله تعالى على نعمه الكثيرة، والاعتراف بفضله علينا.
- المساواة بين الناس: يجمع شهر رمضان بين الفقراء والأغنياء والأمراء والرعية على مائدة الإفطار، مما يعزز المساواة بين الناس.
- التحرر من الشهوات: يساعد الصيام على التحرر من الشهوات والملذات، والتحكم في النفس، مما يزيد من القوة الروحية.
توجيهات قبل قدوم رمضان
لكي نستقبل شهر رمضان المبارك بأفضل حال، ونستفيد من فضائله وبركاته، إليكم بعض النصائح الهامة:
- صدق النية: يجب أن تكون نيتنا صادقة في صيام رمضان إيمانًا واحتسابًا، واغتنام أوقاته في الطاعات والعبادات، والبعد عن المعاصي والمنكرات.
- الدعاء بالتوفيق: ندعو الله تعالى أن يوفقنا لصيام رمضان على الوجه الذي يحبه ويرضاه، وأن يعيننا على قيامه وتلاوة كتابه.
- التوبة والاستغفار: يجب علينا التوبة إلى الله تعالى من جميع الذنوب والمعاصي، والإكثار من الاستغفار والدعاء.
- الابتعاد عن صحبة الكسالى: يجب علينا الابتعاد عن صحبة الكسالى والغافلين، والحرص على مصاحبة الصالحين الذين يعينوننا على الطاعة والعبادة.